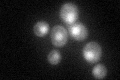
YHR070W
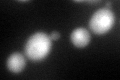
YHR070W
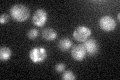
YHR070W

View description
tRNA(m(1)G37)methyltransferase, methylates a tRNA base adjacent to the anticodon that has a role in prevention of frameshifting; highly conserved across Archaea, Bacteria, and Eukarya
Localization:
Intensity:
Fold change:
Significance:
-
C’ GFP library in SD
nucleus:cytosol57.83 -
N' NOP1pr-GFP in SD

cytosol,nucleus126.215 -
N' TEF2pr-mCherry in SD

cell periphery,vacuole0 -
N' NATIVEpr-GFP in SD

nucleus28.5347 -
N' TEF2pr-VC and Cyto-VN in SD

nucleus54.5813 -
C’ GFP library in SD+DTT
nucleus.cytosol51.210.88No -
C’ GFP library in SD+H2O2

nucleus.cytosol55.040.95No -
C’ GFP library in Starvation Media
nucleus,cytosol35.970.62No -
C’ GFP library on the background of Pup2-DaMP

nucleus:cytosol -
C’ GFP library on the background of CCT mutant

nucleus:cytosol73.84141.27678No
